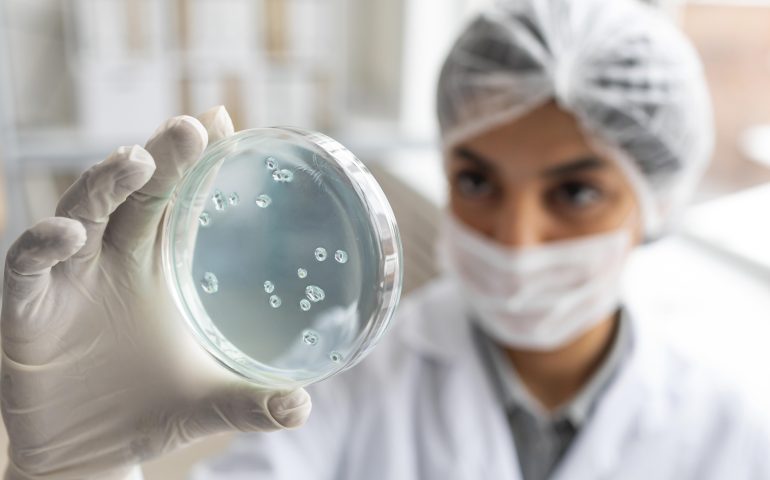
Colombia trabaja unida para combatir la resistencia a los antimicrobianos

Estrategia de Prevención y Reducción de Riesgos y Daños de Sustancias Psicoactivas En 33 municipios de 16 entidades territoriales de Colombia, el Ministerio de Salud y Protección Social desarrolla desde enero del presente año la primera fase de la Estrategia

La OMS presenta datos científicos recientes y nuevas orientaciones sobre la supresión del VIH en la IAS 2023 La Organización Mundial de la Salud (OMS) está presentando nuevos datos científicos y orientaciones normativas sobre el VIH en la 12.ª edición de
Colombia trabaja unida para combatir la resistencia a los antimicrobianos Nuestro país asumió el reto y a través del proyecto Trabajando juntos para combatir la resistencia a los antimicrobianos, financiado por la Unión Europea (UE), y con la asesoría técnica de la

Presión arterial: Importancia, procedimiento y dispositivos para medir la salud cardiovascular La medición de la presión arterial es fundamental en el cuidado de la salud, porque es indicador clave de la fuerza ejercida por la sangre sobre las paredes de

Experiencias para fortalecer la salud nutricional de los colombianos Regulación, información y educación, tres líneas de trabajo compartidas por universidades y cooperantes sobre salud nutricional.El Ministerio de Salud y Protección Social en coordinación con la Embajada de Estados Unidos llevó

¿Cómo identificar una emergencia de salud y a qué tipo de atención médica acudir? Identificar el tipo de atención es primordial para los casos agudos que requieran atención inmediata, así como también establecer un orden y tiempos de la atención,

Minsalud formula estrategia nacional de reducción de consumo de sal/sodio ando alcance a la estrategia nacional de reducción del consumo de sodio, así como a la declaración de la política de "Prevención de las enfermedades cardiovasculares en las Américas, mediante la reducción de la ingesta

Cinco mil millones de personas sin protección frente a las grasas trans están expuestas a enfermedades cardiacas Según revela un nuevo informe de la Organización Mundial de la Salud (OMS), cinco mil millones de personas en todo el mundo siguen

Novedades de las directrices de la OMS sobre el uso de mascarillas los tratamientos y la atención a los enfermos de COVID-19 La Organización Mundial de la Salud (OMS) ha puesto al día sus directrices sobre el uso de mascarillas

Medidas de bioseguridad y vacunación, lo más efectivo contra nueva variante del covid-19 y enfermedades respiratorias debido a ola invernal El Ministerio de Salud y Protección Social propuso retomar el proceso de vacunación de manera continua e hizo recomendaciones a propósito de
Habla con uno de nuestros representantes por WhatsApp o envíanos un correo a info@greysj.com